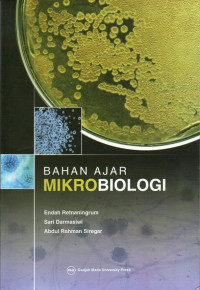
Bahan Ajar Mikrobiologi

Detail Cantuman
Pencarian Spesifik
Text
Bahan Ajar Mikrobiologi
1 Pengantar dan sejarah perkembangan mikrobiologi
2 Metode mikrobiologi
3 Keanekaragaman mikrobia
4 Struktur dan perkembangan mikrobia seluler dan aseluler
5 Nutrisi dan metabolisme mikrobia
6 Pertumbuhan populasi mikrobia
7 Pengendalian pertumbuhan mikrobia
8 Genetika mikrobia
9 Aplikasi mikrobiologi
Ketersediaan
#
Ruang Koleksi (TLM 007)
Belum memasukkan lokasi
2023090004855
Tersedia
Informasi Detail
| Judul Seri |
-
|
|---|---|
| No. Panggil |
616.01 END B
|
| Penerbit | Gadjah Mada University Press : Yogakarta., 2022 |
| Deskripsi Fisik |
xvi, 152 hlm. : Ilus. ; 23 cm.
|
| Bahasa |
Indonesia
|
| ISBN/ISSN |
9786023861750
|
| Klasifikasi |
616.01
|
| Tipe Isi |
-
|
| Tipe Media |
-
|
|---|---|
| Tipe Pembawa |
-
|
| Edisi |
Cet. 4
|
| Subjek | |
| Info Detail Spesifik |
-
|
| Pernyataan Tanggungjawab |
-
|
Versi lain/terkait
Tidak tersedia versi lain
Informasi
Akses Katalog Publik Daring - Gunakan fasilitas pencarian untuk mempercepat penemuan data katalog







